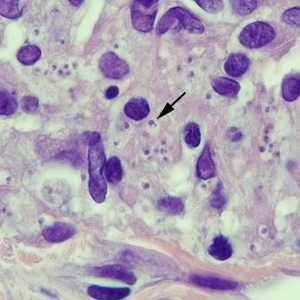

Case #250 - April, 2009
A 45-year-old man developed a few ulcerative lesions on his left forearm about one month after returning from a nature excursion in Costa Rica. He was referred to an infectious disease specialist by his primary care provider. A biopsy was obtained from the rim of one of the lesions, and subsequently sectioned and stained with hematoxylin and eosin (H&E). Figures A and B show what was observed on one of the slides. What is your diagnosis? Based on what criteria? What other testing would you recommend?

Figure A

Figure B
Case Answer
This was a case of cutaneous leishmaniasis caused by Leishmania sp. The main diagnostic feature shown in the images was the presence of amastigotes: small, oval structures in which a nucleus and kinetoplast can be seen (arrow, Figure B). It is not possible to determine the species of Leishmania by the morphology of amastigotes alone. Further testing, such as isoenzyme analysis or PCR, is necessary to identify Leishmania at the species level.
Figure B
More on: Leishmaniasis
Images presented in the monthly case studies are from specimens submitted for diagnosis or archiving. On rare occasions, clinical histories given may be partly fictitious.
DPDx is an education resource designed for health professionals and laboratory scientists. For an overview including prevention and control visit www.cdc.gov/parasites/.
- Page last reviewed: August 24, 2016
- Page last updated: August 24, 2016
- Content source:
- Global Health – Division of Parasitic Diseases and Malaria
- Notice: Linking to a non-federal site does not constitute an endorsement by HHS, CDC or any of its employees of the sponsors or the information and products presented on the site.
- Maintained By:


 ShareCompartir
ShareCompartir